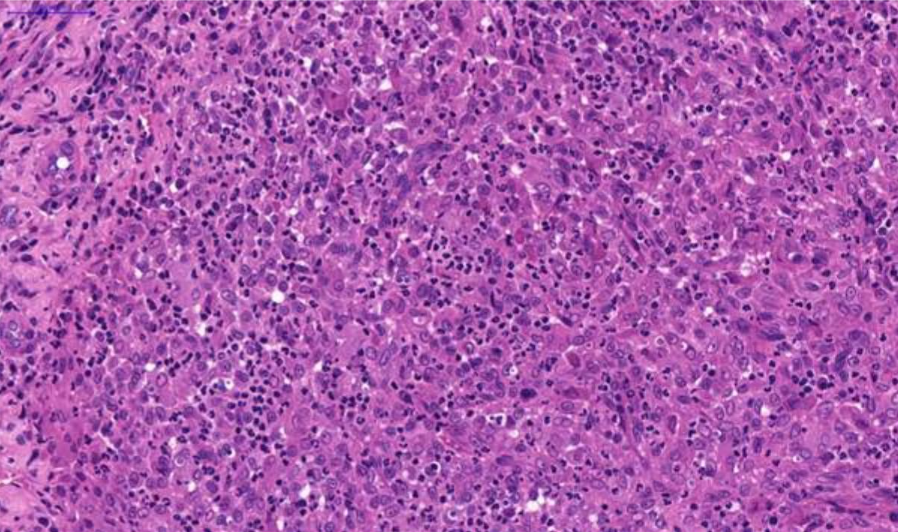

Author: Sofia Clara Sacco DVM, PhD
A six-year-old female Ragdoll cat was examined at a veterinary clinic for a nasal mass. A biopsy measuring 1 cm was performed and submitted to NationWide Laboratories for histopathological evaluation.
The connective tissue of the lamina propria of the nasal cavity was effaced by a diffuse, severe inflammatory infiltrate composed predominantly of numerous macrophages, often epithelioid, with abundant cytoplasm containing basophilic granular material. Interspersed among the macrophages were moderate numbers of neutrophils and fewer lymphocytes. A small section of trabecular bone was present, lined by reactive osteoblasts, neutrophils, and occasional macrophages and lymphocytes. The bone frequently contained a proliferation of elongated cells lacking evident atypia, arranged in bundles and embedded within a moderately collagenous stroma (reactive bone/connective tissue).
Ziehl–Neelsen staining demonstrated intracytoplasmic acid-fast rods within macrophages, consistent with bacteria of the genus Mycobacterium. PCR performed on formalin-fixed tissue was positive for Mycobacterium lepraemurium.

Fig. 1. Nasal tissue, feline. Section of the submitted sample showing severe pyogranulomatous inflammation. H&E stain. Scale bar = 1000 µm.

Fig. 2. Nasal tissue, feline. Severe pyogranulomatous inflammation. H&E stain. Scale bar = 200 µm.
Fig. 3. Nasal tissue, feline. Severe pyogranulomatous inflammation. H&E stain. Scale bar = 50 µm.

Fig. 4. Nasal tissue, feline. Severe pyogranulomatous inflammation. H&E stain. Scale bar = 50 µm.

Fig. 5. Nasal tissue, feline. Nasal tissue showing intracytoplasmic acid-fast rods within macrophages. Ziehl–Neelsen stain. Scale bar = 50 µm.
Based on the microscopic findings, special stains, and PCR results, a diagnosis of severe pyogranulomatous rhinitis with osteomyelitis due to Mycobacterium lepraemurium was made. This organism is the causal agent of feline leprosy.
Microscopically, this sample was consistent with chronic pyogranulomatous inflammation. Ziehl–Neelsen staining demonstrated the presence of intracytoplasmic acid-fast rods within macrophages, highly compatible with Mycobacterium spp., and PCR identified the organism as Mycobacterium lepraemurium. This case illustrates how histology and histochemical techniques can guide diagnosis and highlights the importance of definitive characterisation of the microorganism using PCR. The use of formalin-fixed tissue can be valuable when unfixed samples for culture are not available. Accurate identification of the mycobacterial species has implications for prognosis and treatment of the patient.
Mycobacterial disease in domestic cats can manifest as several distinct syndromes, including tuberculosis (typically caused by Mycobacterium bovis or M. microti), feline leprosy (caused by Mycobacterium lepraemurium and related bacteria), and non-tuberculous mycobacteriosis, resulting from non-tuberculous mycobacteria (NTM) such as Mycobacterium fortuitum and the Mycobacterium avium–intracellulare complex (MAC).
Mycobacterium lepraemurium, a fastidious mycobacterium related to M. avium, can cause either high bacterial index (lepromatous) or low bacterial index (tuberculoid) forms of feline leprosy. Infection is thought to occur following contact with rodents, which inoculate infectious propagules into the dermis or subcutis of the cat. This pathogen shows a predilection for structures of the head and forelimbs, generally sparing ocular tissues and periocular skin. The clinical course in most cats is indolent, with no evidence of internal organ involvement based on clinical criteria. Occasionally, widespread cutaneous nodules are observed, suggestive of haematogenous dissemination.
Treatment regimens have varied; nevertheless, cats generally respond favourably, particularly to surgical excision combined with long-term administration of two or more antimicrobials effective against slow-growing mycobacteria. To date, there have been no reported cases of direct cat-to-cat transmission.
O’Brien CR, Malik R, Globan M, Reppas G, McCowan C, Fyfe JA. Feline leprosy due to Mycobacterium lepraemurium. J Feline Med Surg. 2017 Jul;19(7):737-746. doi: 10.1177/1098612X17706469. PMID: 28592223; PMCID: PMC11129200.
Mycobacterial disease in cats in Great Britain: I. Culture results, geographical distribution and clinical presentation of 339 cases. Gunn-Moore DA, McFarland SE, Brewer JI, Crawshaw TR, Clifton-Hadley RS, Kovalik M, Shaw DJ. J Feline Med Surg. 2011 Dec;13(12):934-44. doi: 10.1016/j.jfms.2011.07.012. Epub 2011 Nov 10. PMID: 22079343; PMCID: PMC10832973.
Mycobacterial disease in a population of 339 cats in Great Britain: II. Histopathology of 225 cases, and treatment and outcome of 184 cases. Gunn-Moore DA, McFarland SE, Schock A, Brewer JI, Crawshaw TR, Clifton-Hadley RS, Shaw DJ. J Feline Med Surg. 2011 Dec;13(12):945-52. doi: 10.1016/j.jfms.2011.09.009. Epub 2011 Nov 6. PMID: 22061264; PMCID: PMC10832975.